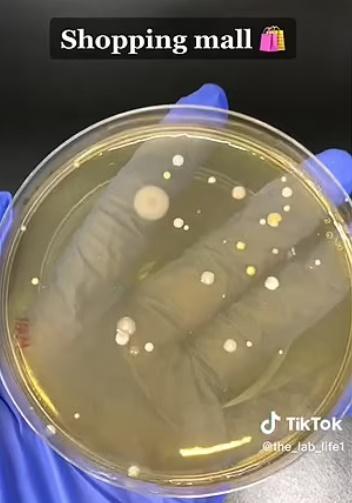
商場洗手間吹風機。(TikTok)
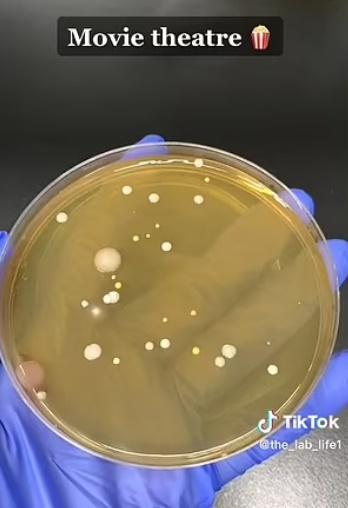
戲院洗手間吹風機。(TikTok)

洗完手用吹風機吹乾,專家實驗證或將細菌吹回手上。(TikTok)
現時部分公廁或洗手間都不會提供抹手紙,只會提供吹風機以讓人吹乾雙手,不過,外國一名專家卻發現,用吹風機雖然能將手吹乾,但可能反而將空氣中的細菌都吹回剛洗完的手上。
綜合報道,TikTok用戶@the_lab_life1經常分享各種實驗影片。她近日在商場、電影院和公司的吹風機採集樣本,與實驗室中的培養皿樣本做比較,發現除了自然風乾的培養皿沒有細菌之外,其他的培養皿上都有細菌,原因不是吹風機沾有細菌,而是吹風機將細菌吹到手上。影片未有透露發現的是哪種細菌,不過之前有研究曾指出公廁有流感病毒、鏈球菌、具抗藥性金黃色葡萄球菌、沙門氏菌、志賀氏菌和諾羅病毒。
網民:吹風機將所有細菌都吹到手上
影片獲得逾200 萬個讚和逾 12,000 條評論,不少網民評論反映對這次發現感到震驚,有網民說:「(吹風機)將洗手間的所有細菌都吹到手上」、「這就是為甚麼我寧願雙手滴著水離開洗手間」。
2018年一份康乃狄克大學與昆尼皮亞克大學共同執行的研究發現,將裝有「細菌食物」的培養皿放在無吹風機的洗手間裡,18個小時內就長出6個病原體菌;但用吹風機烘乾30秒後,培養皿的病原體菌則高達254個。西敏大學首席研究作者Keith Redway博士表示,所有將手弄乾的方法中,用抺手紙抺乾所傳播的微生物量為最少。